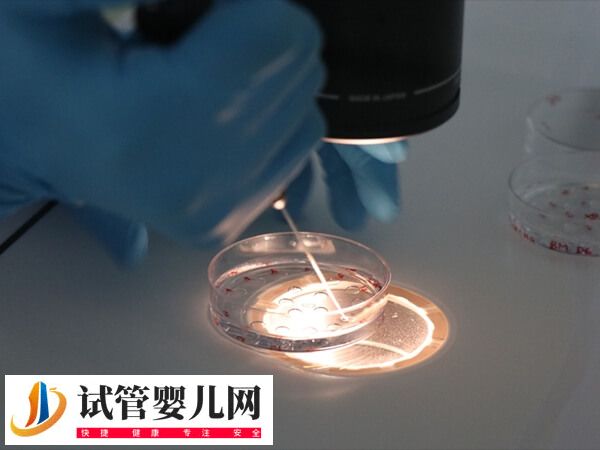
3代试管婴儿能否排除唇腭裂(图2)

第三代试管婴儿技术能够在一定程度上帮助排除唇腭裂,但并非完全可靠。这是因为三代试管存在一定的技术限制,并不能百分百提高优生优育的几率,大概在80%-90%,同时唇腭裂的发生不仅仅由遗传因素决定,还可能受到环境因素的影响,所以做3代试管婴儿并不能完全排除唇腭裂的发生几率。

3代试管婴儿排除唇腭裂的几率
唇腭裂也被俗称为兔唇,是基因变异造成的遗传性疾病,此疾病具有遗传倾向。那么第三代试管婴儿的胚胎植入前遗传学诊断技术能避免遗传因素导致的唇腭裂吗,如下所示:
- 在第3代试管婴儿技术支持的前提下,可以对于移植的胚胎在第一阶段进行基因筛选。一般做第三代试管婴儿可以避免遗传因素导致的唇腭裂,然后进行筛选出健康胚胎进行移植,从而可以尽量的减少遗传性疾病发生的可能;
- 唇腭裂不只是先天性畸形,还有一部分是外界因素,所以患者在备孕前后或妊娠期,有服用各种药物的副作用,怀孕期间抽烟、饮酒,密切接触化学药物、过多接触放射线都可能造成宝宝先天性唇腭裂,这时通过三代不能排除唇腭裂。
唇腭裂的发生并不是单一因素导致的,而是由遗传和其他因素共同影响的结果。如果直系或旁系亲属中有类似畸形发生,就可能携带致病基因。所以在怀孕期间做好产检,加强营养以及孕妇个人保护是重点。
唇腭裂的遗传几率
如果女性是唇腭裂的话,遗传的几率高达14%左右,男性患有唇腭裂的话,遗传的几率在3%左右。如果健康的夫妻生育了一个兔唇宝宝,再次生育患有兔唇的几率仍在4%左右。倘若是近亲结婚的话,发病的几率就会更高。
在生育过程中,有相关数据限制,在大多数患儿可以发现在其直系亲属或旁系中,也有同样畸形发生。所以建议可能产出唇腭裂的夫妇选择三代试管助孕,尽可能的规避一部分风险。因此建议妊娠的患者,在妊娠期间一定要好好保护自己。保证营养充分摄入,心态要保持平和,做好产检,才能尽可能的避免这些情况。
3代试管婴儿优生优育的几率
三代试管婴儿技术旨在通过遗传学筛查来优化胚胎质量,从而提高优生优育的几率。根据最新的搜索结果,三代试管婴儿的成功率通常在40%-70%之间,具体成功率会受到多种因素的影响,包括患者的年龄、胚胎质量、子宫环境以及医疗机构的技术水平等。
此外,3代试管婴儿优生优育的几率还与经验丰富的医疗机构和医生有关,如果是经验丰富的医生,其优生的几率可能在50%-70%之间。但技术水平一般的医疗机构和医生,成功率可能在40%-55%之间。而且心态积极乐观的患者,成功率可达到45%-65%。但心理负担重的患者,成功率可能降低,约在30%-50%之间。






